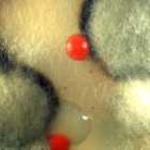
Wie gelangen Schimmelpilze in L&uuml;ftungsanlagen?
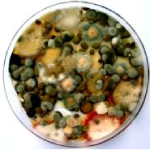
Welche gesundheitlichen Risiken gehen von Schimmelpilzen aus?
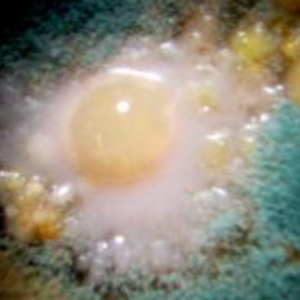
Wie erkennt man Schimmel in einer L&uuml;ftungsanlage?
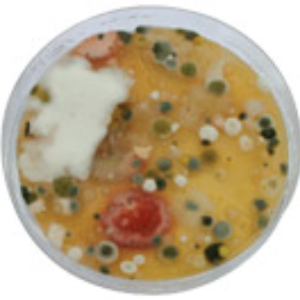
Hygieneinspektionen nach VDI 6022
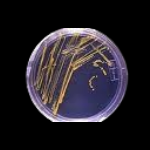
Professionelle Unterst&uuml;tzung durch Fa. Akut

Schimmelpilze in Lüftungsanlagen
Kurz zusammengefasst
Schimmelpilze in Lüftungsanlagen können die Raumluftqualität erheblich beeinträchtigen und gesundheitliche Beschwerden auslösen. Besonders in raumlufttechnischen Anlagen (RLT-Anlagen) vermehren sich Mikroorganismen und verteilen sich über die Luft im gesamten Gebäude.
Regelmäßige Hygieneinspektionen, Wartung und professionelle Reinigung sind daher entscheidend, um Belastungen frühzeitig zu erkennen und zu beseitigen. Wir unterstützen Sie dabei, Ihre Lüftungsanlagen hygienisch einwandfrei zu betreiben und die gesetzlichen Anforderungen – etwa nach VDI 6022 – zuverlässig einzuhalten.
Warum Schimmelpilze in Lüftungsanlagen ein ernstes Problem sind
Lüftungs- und Klimasysteme sorgen in modernen Gebäuden für frische Luft und ein angenehmes Raumklima. Gleichzeitig können sie jedoch auch zu einer Quelle mikrobiologischer Belastungen werden. Wenn Feuchtigkeit, Staub und organische Partikel zusammentreffen, entstehen ideale Bedingungen für Schimmelpilze.
Gerade in schwer zugänglichen Bereichen von Lüftungsanlagen bleibt ein Befall oft lange unentdeckt. Die entstehenden Sporen werden über die Luftströmung verteilt und gelangen so in Büros, Wohnungen oder öffentliche Gebäude. Das kann nicht nur die Luftqualität beeinträchtigen, sondern auch gesundheitliche Risiken für die Nutzer mit sich bringen.

Wie gelangen Schimmelpilze in Lüftungsanlagen?
Schimmelpilze sind natürlicher Bestandteil unserer Umwelt. Ihre Sporen befinden sich ständig in der Außenluft und gelangen beim Lüften oder über Ansaugöffnungen in Lüftungssysteme. Normalerweise werden sie durch Filter zurückgehalten oder über den Luftstrom wieder nach außen transportiert.
Problematisch wird es, wenn sich im Inneren der Anlage Feuchtigkeit bildet oder Verschmutzungen ansammeln. Staub, Pollen oder organische Ablagerungen können dann als Nährboden dienen. In Kombination mit Kondenswasser entsteht ein Milieu, in dem sich Schimmelpilze vermehren.
Welche Ursachen führen zu Schimmelbildung in RLT-Anlagen?
Mehrere Faktoren können die Entstehung von Schimmel in raumlufttechnischen Anlagen begünstigen:
- unzureichende Wartung und Reinigung
- verschmutzte oder beschädigte Filter
- Kondenswasserbildung in Luftkanälen
- falsche Luftfeuchtigkeit oder Temperatur
- bauliche Mängel im Lüftungssystem
Welche gesundheitlichen Risiken gehen von Schimmelpilzen aus?
Schimmelpilze können verschiedene gesundheitliche Auswirkungen haben. Besonders empfindliche Personen reagieren häufig mit allergischen Beschwerden oder Reizungen der Atemwege.
Die Belastung entsteht vor allem durch Sporen und Stoffwechselprodukte der Mikroorganismen, die über die Luft eingeatmet werden. Je nach Konzentration können Symptome wie Husten, Kopfschmerzen oder Müdigkeit auftreten.
Eine gute Raumluftqualität ist daher ein wichtiger Bestandteil des Gesundheits- und Arbeitsschutzes in Gebäuden.

Wie erkennt man Schimmel in einer Lüftungsanlage?
Ein Befall ist häufig nicht sofort sichtbar. Typische Hinweise können jedoch sein:
- auffälliger oder muffiger Geruch
- erhöhte Staub- oder Partikelbelastung
- wiederkehrende gesundheitliche Beschwerden bei Nutzern
- sichtbare Ablagerungen an Luftauslässen oder Filtern
Die Rolle von Wartung und Reinigung
Regelmäßige Wartung und Reinigung sind entscheidend, um Schimmelbildung in Lüftungsanlagen zu verhindern. Dabei werden unter anderem Filter kontrolliert, Luftkanäle überprüft und Verschmutzungen entfernt.
Durch diese Maßnahmen lassen sich potenzielle Risiken frühzeitig erkennen und beseitigen. Gleichzeitig stellen Sie sicher, dass die Anlage effizient arbeitet und die gewünschte Luftqualität gewährleistet.
Hygieneinspektionen nach VDI 6022
In Deutschland regelt die Richtlinie VDI 6022 die hygienischen Anforderungen an raumlufttechnische Anlagen. Sie beschreibt unter anderem, in welchen Abständen Anlagen überprüft werden müssen und welche Maßnahmen bei Auffälligkeiten erforderlich sind.
Eine Hygieneinspektion von Fa. Akut umfasst beispielsweise:
- Sichtprüfung der Anlagenkomponenten
- mikrobiologische Untersuchungen
- Bewertung der Raumluftqualität
- Dokumentation des hygienischen Zustands
Diese Inspektionen tragen dazu bei, gesundheitliche Risiken frühzeitig zu erkennen. Sichern Sie die Gesundeit Ihres Teams, Ihrer Kunden und Geschäftspartner ab und lassen Sie sich umfassend zu unseren Leistungen beraten.

Vorbeugung statt Sanierung
Eine professionelle Wartungsstrategie hilft, Schimmelpilze gar nicht erst entstehen zu lassen. Dazu gehören regelmäßige Kontrollen, der rechtzeitige Austausch von Filtern sowie eine fachgerechte Reinigung der Anlage.
Vorbeugende Maßnahmen sind meist deutlich wirtschaftlicher als eine nachträgliche Sanierung. Zudem schützen sie die Nutzer eines Gebäudes zuverlässig vor gesundheitlichen Belastungen.
SCHIMMELPILZE IN LÜFTUNGSANLAGEN
SCHIMMELPILZE – ALLGEMEINE INFORMATIONEN
Allergien und ähnliche Erkrankungen nehmen seit Jahren zu. In Deutschland ist die Zahl der Allergiker auf über 30 Millionen gestiegen. Ca. 30% dieser Allergiker sind von einer Schimmelpilzallergie betroffen.
Die in der Außen-/Atemluft natürlich vorkommenden Sporen der Schimmelpilze gelangen u.a. durch Lüftungsanlagen (RLT-Anlagen) in die Raumluft. Deshalb gewinnen der Arbeitsplatz, die Wohnung, das Haus und öffentliche Gebäude (z.B. Krankenhäuser, Schulen und Kindergärten) als Einflussfaktor für allergene Erkrankungen an Bedeutung.

Inzwischen ist bei Wissenschaftlern und Sachverständigen die Erkenntnis gereift, dass mikrobiologische Kontaminationen, wie z.B. durch Schimmelpilz/-sporen, schwere Gesundheitsstörungen hervorrufen und sogar verstärken können.
Schimmelpilze und deren Sporen haben unterschiedlich gesundheitsschädigende Einflüsse:
- allergene Wirkungen
- toxische Wirkungen
- infektiöse Wirkungen
- Geruchsbelästigung
- Zwischen allergischen Reaktionen wie
- Reizungen der Augen und Atemwege,
- Kopfschmerzen,
- Müdigkeit und Gliederschmerzen und dem Vorhandensein von Schimmelpilzarten in Räumen besteht nachweislich ein Zusammenhang.
Die Raumluft an Arbeitsplätzen, in Häusern und Wohnungen kann krank machen!
Schimmelpilze entwickeln sich oft an verborgenen Stellen wie z.B. in schwer einsehbaren Lüftungsanlagen. Sie werden deshalb häufig als mögliche Ursache von gesundheitlichen Beschwerden der Betroffenen außer Acht gelassen.
Ein wirksamer Schutz vor mikrobiellen Belastungen und Erkrankungen beginnt aber bereits bei den vorbeugenden Maßnahmen.
Die regelmäßige Hygieneinspektion nach VDI 6022 liefert umfassende Informationen über eine der Gesundheit zuträglichen Raumluftqualität und einer möglichen gesundheitlichen Gefährdung.
Professionelle Unterstützung durch Fa. Akut
Wenn Schimmelpilze in Lüftungsanlagen auftreten oder der Verdacht auf eine mikrobiologische Belastung besteht, ist eine fachgerechte Untersuchung unerlässlich. Wir unterstützen Sie bei der Bewertung des hygienischen Zustands Ihrer Anlage und entwickeln passende Maßnahmen zur Reinigung und Sanierung.
Mit moderner Technik und qualifiziertem Fachpersonal sorgen wir dafür, dass Ihre Lüftungsanlagen wieder hygienisch einwandfrei arbeiten und die Raumluftqualität dauerhaft verbessert wird.
Wie gefährlich sind Schimmelpilze in Lüftungsanlagen?
Wie entstehen Schimmelpilze in Lüftungsanlagen?
Wie erkennt man Schimmel in einer Lüftungsanlage?
Wie oft sollten Lüftungsanlagen hygienisch überprüft werden?
Was tun bei Verdacht auf Schimmel in der Lüftungsanlage?
Wir beraten Sie gern: Schreiben Sie uns, nutzen Sie unser Kontaktformular oder rufen Sie einfach an.

 Dann rufen Sie uns an unter:
Dann rufen Sie uns an unter:
